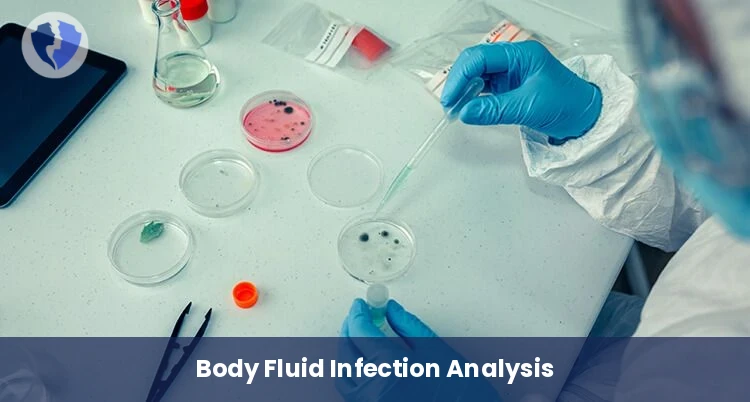
Body Fluid Culture Test - Body Fluid Culture and Sensitivity

Service Details
Body Fluid Culture Test - Body Fluid Culture and Sensitivity
A comprehensive diagnostic package includes: First, direct microscopic examination and culture of a sterile body fluid sample (pulmonary, peritoneal, articular, pericardial, etc.) on suitable nutrient media to detect bacterial or fungal growth. Second, susceptibility testing of any isolated organism to determine the most appropriate antibiotic or antifungal for the leech.